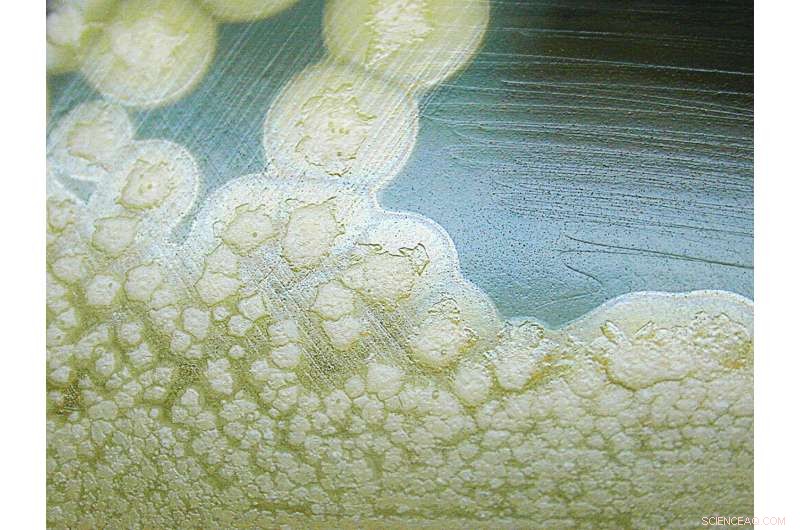
New Copper Compound Neutralizes Botulinum Neurotoxin, Offering Hope Against Poisoning

The Clostridium botulinum bacterium (shown here in colonies) can cause foodborne illnesses and potentially deadly effects due to the neurotoxin it produces. Credit: CDC
Botulinum neurotoxin is probably best known to Americans as BOTOX, a cosmetic medicine, rather than as a cause of potentially dangerous foodborne illnesses. Lesser known is that Clostridium botulinum, the bacterium that causes the neurointoxication, produces one of the most potent toxins on earth and is classified as a potential bioterrorism threat.
While no cure exists—and botulism treatment options are limited—a serendipitous discovery by scientists at The Scripps Research Institute (TSRI) may provide a new therapy that can stop the neurotoxin even in its more severe, advanced stages of action. The finding, based on rodent studies, was published recently in the Journal of the American Chemical Society.
Lead scientist Kim Janda, the Ely R. Callaway, Jr. Professor of Chemistry at TSRI, said he decided to explore botulism neurotoxin due to its debilitating and life-threatening effects, as well as its danger as a potential bioterrorism agent. "It's on the same level as Anthrax, Plague, Ebola and other Category A priority pathogens," Janda said, referring to the Centers for Disease Control and Prevention's (CDC) list of biological agents of highest concern. "Yet there is nothing even in phase I clinical trials."
Botulism is a rare but serious disorder that attacks the body's ability to signal to muscles. Symptoms include blurry vision, slurred speech, muscle weakness and difficulty swallowing. It can lead to paralysis throughout the body, and even death by affecting the patient's ability to breathe. According to the CDC, botulism is primarily transmitted through food or wounds infected by the botulism bacteria, which lives in the environment. In extremely small doses, the botulism toxin is injected for medical purposes, such as to relieve spasticity, and as a cosmetic wrinkle treatment.
To discover potential inhibitors of the toxin, Janda and his research team screened triazole compounds against the botulinum neurotoxin light chain, a proteolytic enzyme that disrupts neuronal signaling to muscles. The triazoles were synthesized using click chemistry—a method developed by TSRI Professor and Nobel laureate K. Barry Sharpless in the mid-1990s. Paul Bremer, a graduate student working in Janda's laboratory and the study's first author, said they hit upon a triazole compound provided by Sharpless's laboratory that appeared to forcefully inhibit the toxin light chain in an enzymatic assay.
Further testing revealed a surprise. "We had found what we thought were active click compounds, but really they were only active because of the copper," Bremer said. Copper is used as a catalyst to accomplish click chemistry and trace amounts would not be anticipated to show activity in a bioassay, he explained. "Upon further experiments, it came as a complete surprise that copper was quite potently inhibiting the enzyme."
The scientists had accidentally landed upon a potential new therapy for type A of the neurotoxin, the most common and deadly cause of human botulism, using copper chloride, an inexpensive, readily available metal salt as the active ingredient.
Next, the researchers designed molecules called ligands to act as delivery vehicles for copper into neuronal cells, an essential step in translating the therapeutic action of copper to biological systems. The TSRI team then sent their ligand-copper complexes to their study collaborators at the University of Wisconsin-Madison, who administered it to mice. The compound extended the animals' lives, even when they were given lethal doses of the toxin.
The researchers said further animal testing is needed to determine optimal dosage, dosing frequency and other factors. Janda said clinical trials to prove efficacy cannot be done in humans due to botulinum neurotoxicity dangers. However, the safety of the copper complex can be validated through several other clinical trials already underway for different uses, he added.
If found to be safe, Bremer said the copper therapeutic could provide a more effective therapy than existing approaches to botulism. Currently, botulism sufferers receive an anti-toxin medicine that can inactivate the toxin circulating in their system, thereby preventing further poisoning. However, the anti-toxin cannot reverse preexisting paralysis because the toxin acts inside cells. Consequently, disease recovery can be slow, and paralysis may take weeks or months to wear off.
"The anti-toxin is antibody-based, which means it only works outside the cells," said Janda. "This new therapy can readily enter cells where it can attack the etiological agent, a protease, which is responsible for paralysis seen from the neurotoxin."
The researchers also noted that the study further demonstrates the need to explore metals for therapeutic uses. Metals are not commonly used in drug design because of concerns about toxicity and specific targeting as compared to organic compounds. However, several metal-based therapies already exist. For instance, gold is used in therapies for certain cancers and rheumatoid arthritis, while other metal-based treatments are currently in clinical trials.
"These are kind of underappreciated medicinal agents," said Bremer. "Our work shows the need to explore their potential further."